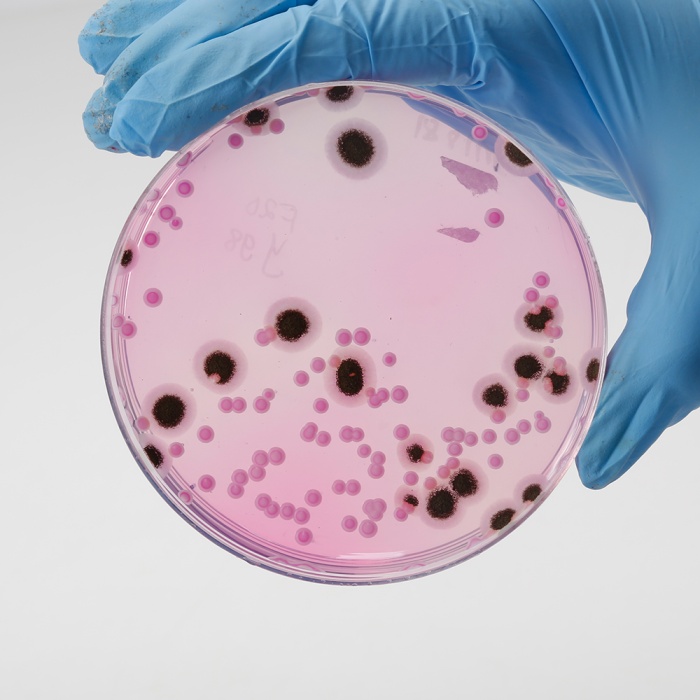

Your enquiry has been submitted
Dichloran Rose Bengal Chloramphenicol Agar (DRBC Agar)
Intended Use
Recommended for selective isolation of fungi-yeasts and moulds of significance in food spoilage. The composition and performance criteria are in accordance with ISO 21527-1 and ISO 11133:2014 (E) /Amd. :2020.
Composition
| Ingredients | g / L |
|---|---|
| Peptone$ | 5.000 |
| Dextrose (Glucose) | 10.000 |
| Potassium dihydrogen phosphate | 1.000 |
| Magnesium sulphate | 0.500 |
| Rose Bengal | 0.025 |
| Chloramphenicol | 0.100 |
| Dichloran | 0.002 |
| Agar | 15.000 |
pH after sterilization (at 25°C): 5.6±0.2
**Formula adjusted, standardized to suit performance parameters
$ - Equivalent to Enzymatic digest of animal & plant tissues
Directions
Suspend 31.63 gram in 1000 ml purified/distilled water. Heat to boiling to dissolve the medium completely. Sterilize by autoclaving at 15 lbs pressure (121°C) for 15 minutes. Cool to 45-50°C. Mix well and pour into sterile Petri plates.
Principle And Interpretation
Dichloran Rose Bengal Chloramphenicol Agar (DRBC Agar) is formulated as described by King et.al (1) and is recommended for selective isolation of yeasts and moulds especially in food and animal feeding samples. It is recommended by ISO (2). This medium is a modification of Rose Bengal Chloramphenicol Agar which additionally contains dichloran.
Peptone provides nitrogeneous compounds, carbon, long chain amino acids, vitamins and other essential growth nutrients. Dextrose (Glucose) is a carbohydrate source. Phosphate buffers the medium. Magnesium sulfate provides divalent cations and sulfate. Dichloran is an antifungal agent, added to the medium to reduce colony diameters of spreading fungi. Rose Bengal exhibits an improved inhibitory activity at pH 5.6 and hence the final pH of the medium is maintained at 5.6 for the inhibition of spreading fungi (1). The presence of rose bengal in the medium suppresses the growth of bacteria and restricts the size and colonies of the more rapidly growing moulds. Chloramphenicol is included to inhibit the growth of bacteria present in environmental and food samples. Inhibition of growth of bacteria and restriction of spreading of more-rapidly growing moulds aids in the isolation of slow-growing fungi by preventing their overgrowth by more-rapidly growing species. Additionally Rose Bengal is taken by yeast and moulds colonies, which allows these colonies to be easily recognized and enumerated. This medium should not be exposed to direct light as rose bengal undergoes photo-degradation leading to formation of toxic chemicals for fungi (3,4).
Type of specimen
Food sample: Eggs, Meat, Dairy products (except milk powder), Fruits, Vegetables, Fresh pastes, animal feeds, etc.
Specimen Collection and Handling
For food and dairy samples, follow appropriate techniques for sample collection and processing as per guidelines (2, 3, 5, 6, 7). After use, contaminated materials must be sterilized by autoclaving before discarding.
Warning and Precautions
Read the label before opening the container. Wear protective gloves/protective clothing/eye protection/ face protection. Follow good microbiological lab practices while handling specimens and culture. Standard precautions as per established guidelines should be followed while handling specimens. Safety guidelines may be referred in individual safety data sheets.
Limitations
- Individual organisms differ in their growth requirement and may show variable growth patterns on the medium.
- Further biochemical identification is necessary for confirmation.
Performance and Evaluation
Performance of the medium is expected when used as per the direction on the label within the expiry period when stored at recommended temperature.
Quality Control
Appearance: Light yellow to pink homogeneous free flowing powder
Gelling: Firm, comparable with 1.5% Agar gel
Colour and Clarity of prepared medium: Pink coloured, clear to slightly opalescent gel forms in Petri plates
Reaction: Reaction of 3.16% w/v aqueous solution at 25°C. pH : 5.6±0.2
pH: 5.40-5.80
Cultural Response:
Productivity: Cultural characteristics observed after an incubation at 25 ± 1°C for 5 days. Recovery is considered as 100% for fungi growth on Reference medium -Sabouraud Dextrose Agar.
Selectivity: Cultural characteristics observed after an incubation at 25 ± 1°C for 5 days.
| Organism | Inoculum (CFU) | Growth | Recovery |
|---|---|---|---|
| Productivity | |||
| Saccharomyces cerevisiae ATCC 9763 (00058)* # | 50-100 | good-luxuriant | >=50% |
| Aspergillus brasiliensis ATCC 16404 (00053)* # | 50-100 | good-luxuriant | >=50% |
| Candida albicans ATCC 10231 (00054)* | 50-100 | good-luxuriant | >=50% |
| Mucor racemosus ATCC 42647 (00181)* | good-luxuriant | ||
| Selectivity | |||
| Bacillus spizizenii ATCC 6633 (00003)* $ | >=104 | inhibited | |
| Escherichia coli ATCC 25922 (00013)* | >=104 | inhibited | |
| Escherichia coli ATCC 8739 (00012)* | >=104 | inhibited | |
Key : (*) - Corresponding WDCM numbers
$ - Formerly known as Bacillus subtilis subsp. spizizenii
# Formerly known as Aspergillus niger
Storage and Shelf Life
Store between 15-25°C in a tightly closed container and the prepared medium at 2-8°C. Use before expiry date on the label. On opening, product should be properly stored dry, after tightly capping the bottle in order to prevent lump formation due to the hygroscopic nature of the product. Improper storage of the product may lead to lump formation. Store in dry ventilated area protected from extremes of temperature and sources of ignition Seal the container tightly after use. Product performance is best if used within stated expiry period.
Disposal
User must ensure safe disposal by autoclaving and/or incineration of used or unusable preparations of this product. Follow established laboratory procedures in disposing of infectious materials and material that comes into contact with sample must be decontaminated and disposed of in accordance with current laboratory techniques (8,9).
Reference
- King D.A. Jr., Hocking A.D. and Pitt J.I., 1979, J. Appl. Environ. Microbiol., 37:959.
- Microbiology of food and animal feeding stuffs -- Horizontal method for the enumeration of yeasts and moulds -- Part 1: Colony count technique in products with water activity greater than 0,95, ISO 21527-1:2008
- Salfinger Y., and Tortorello M.L. Fifth (Ed.), 2015, Compendium of Methods for the Microbiological Examination of Foods, American Public Health Association, Washington, D.C.
- Sharp A.N. and Jackson A.K., 1972, J. Appl. Bact., 24:175.
- American Public Health Association, Standard Methods for the Examination of Dairy Products, 1978, 14th Ed., Washington D.C.
- Wehr H. M. and Frank J. H., 2004, Standard Methods for the Microbiological Examination of Dairy Products, 17th Ed., APHA Inc., Washington, D.C.
- Microbiology of food,animal feeding stuffs and water- Preparation, production,storage and performance testing of culture media, EN ISO 11133:2014 (E) /Amd. 1:2020.
- Isenberg, H.D. Clinical Microbiology Procedures Handbook 2nd Edition.
- Jorgensen, J.H., Pfaller, M.A., Carroll, K.C., Funke, G., Landry, M.L., Richter, S.S and Warnock., D.W. (2015) Manual of Clinical Microbiology, 11th Edition. Vol. 1.
| Product Name | Dichloran Rose Bengal Chloramphenicol Agar (DRBC Agar) |
|---|---|
| SKU | M1881 |
| Product Type | Regular |
| Physical Form | Powder |
| Origin | Animal |
| Packaging type | HDPE |
| References | 1.King D.A. Jr., Hocking A.D. and Pitt J.I., 1979, J. Appl. Environ. Microbiol., 37:959.2.Sharp A.N. and Jackson A.K., 1972, J. Appl. Bact., 24:175.3.U.S. Food and Drug Administration, 1995, Bacteriological Analytical Manual, 8th Ed., AOAC International, Gaithersburg,Md. |
| Customized Product Available | No |